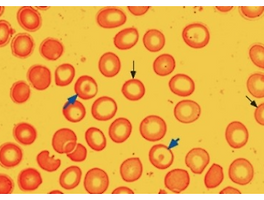

728x90
반응형

Pernicious anemia (PA)는 종종 추가적인 자가면역 조건들과 관련이 있습니다. 해설에 언급하였던 polyglandular autoimmune syndrome type 2와 chronic atrophic gastritis입니다.Chronic atrophic gastritis는 antiparietal cell antibodies 때문입니다. Food cobalamin malabsorption은 음식에 정상적인 비타민 B12가 있음에도 불구하고 비타민 B12 결핍 상태를 나타내는 용어로서 주된 문제는 음식 단백질로부터 비타민 B12를 분리하지 못하기 때문입니다. 따라서 단백질과 결합되어 있지 않은 비타민 B12 보충제는 흡수할 수 있습니다. 이 환자들은 다음과 같은 조건들과 관련되어 있습니다. Atrophic gastritis; gastric surgery; chronic H. pylori infection; achlorhydria from chronic use of antacids, H2 receptor blockers, proton pump inhibitors; chronic excess alcohol use; pancreatic insufficiency; antibiotic use with intestinal bacterial overgrowth.
REF. UpToDate 2020.04.19
728x90
반응형
'혈액내과 > 조혈' 카테고리의 다른 글
| 재생불량성빈혈, 치료 선택, Aplastic anemia, treatment (0) | 2020.04.19 |
|---|---|
| Megaloblastic anemia, neurologic finding in vitamin B12 deficiency (0) | 2020.04.19 |
| Nondialysis CKD 환자에서 철분제 공급과 ESA 투약 시작 기준 (0) | 2020.04.19 |
| Microcytic anemia 감별 ㈀ iron deficiency, ㈁ alpha 또는 beta thalassemia minor ㈂ anemia of inflammation (0) | 2020.04.19 |
| 철결핍성빈혈 가능성 (0) | 2020.04.19 |